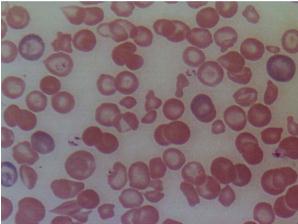
Smear.

Rac GTPases and Red Blood Cell Cytoskeleton
Many of the roles of Rac1 and Rac2 GTPases are mediated through regulation of actin organization. Using a mouse gene targeting approach, we demonstrated that the concurrent deficiency of Rac1 and Rac2 GTPases in RBCs causes profound disruption of actin assembly and abnormal deformability of the erythrocyte cytoskeleton. Rac1-/-;Rac2-/- mice develop microcytic hemolytic anemia with poikilocytosis and RBC fragmentation.
This is associated with increased phosphorylation of adducin at Ser-724, a domain target of protein kinase C (PKC) (Kalfa et al. Blood. 108(12):3637-3645. 2006). These findings point to the exciting possibility that the erythrocyte cytoskeleton is a dynamic assembly regulated by signaling molecules, which actively participate in a continuous repair of the cytoskeleton under flow conditions, and assure normal survival of the erythrocytes in the circulation.